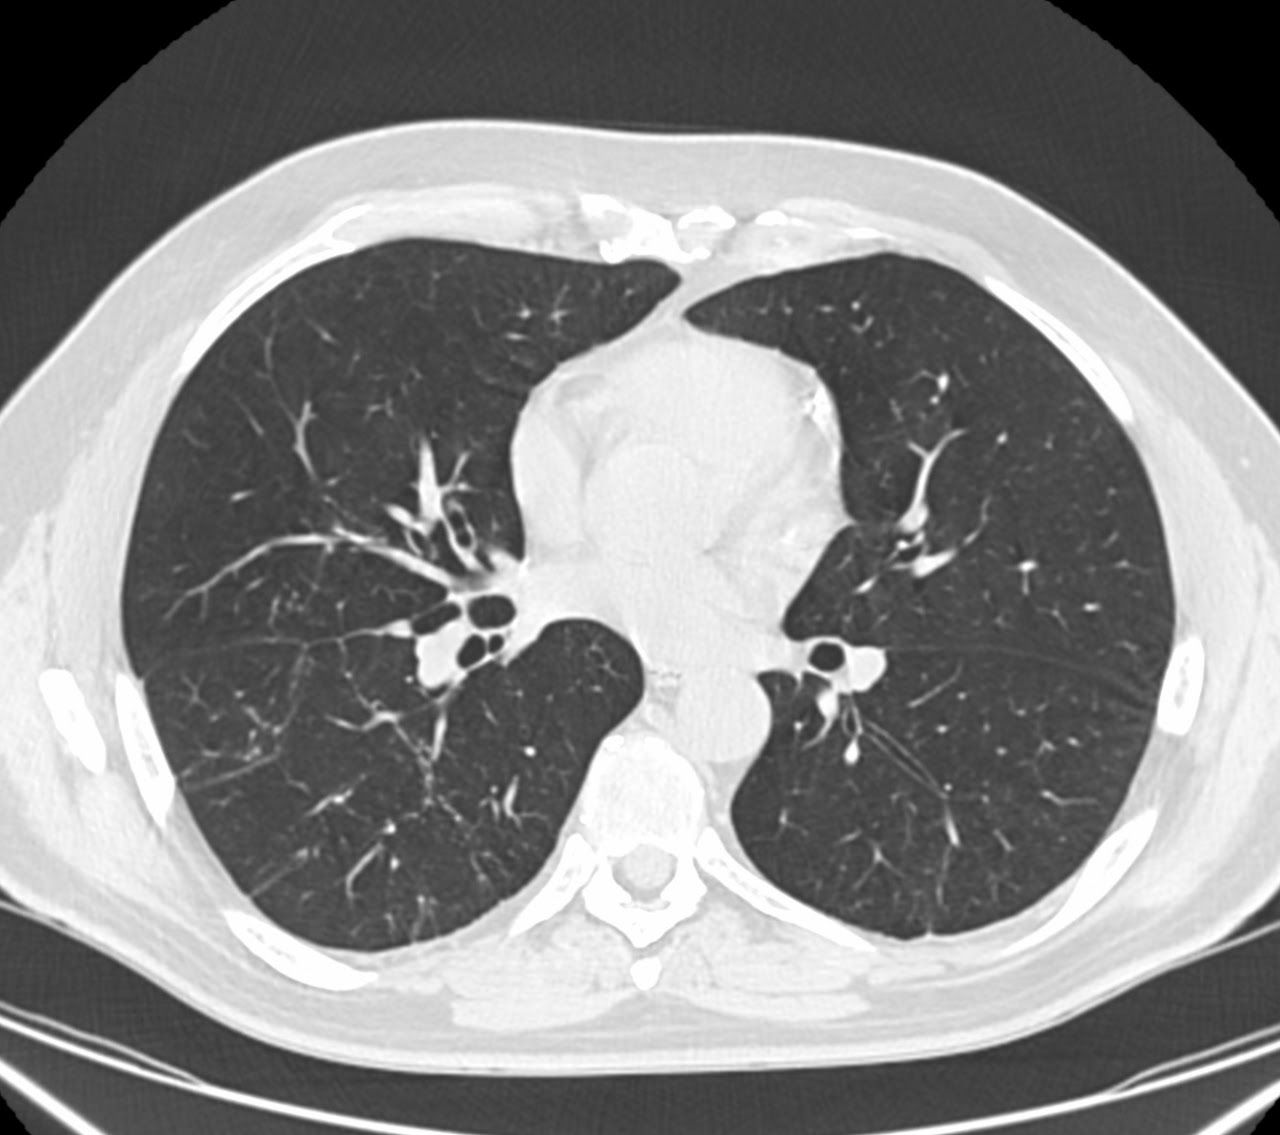
Tomografía de tórax ventana pulmonar

Dr. Homero Corral
Seguridad, confianza y certeza en diagnóstico por imagen. Más de 15 años de experiencia brindando ultrasonido especializado y segundas opiniones con criterio clínico de alto nivel.
Seguridad, confianza y certeza en diagnóstico por imagen. Más de 15 años de experiencia brindando ultrasonido especializado y segundas opiniones con criterio clínico de alto nivel.
Tecnología de vanguardia y criterio clínico para resultados certeros y oportunos. Haz clic en cualquier imagen para verla en detalle.
 Tendón Supraespinoso — Hombro Izq.
Tendón Supraespinoso — Hombro Izq.
 Vesícula Biliar
Vesícula Biliar
 TAC Abdomen — Coronal
TAC Abdomen — Coronal
TAC Tórax — Ventana Pulmonar
TAC Tórax — Ventana Pulmonar
 RM Cerebro — Coronal
RM Cerebro — Coronal

Soy médico especialista en Radiología e Imagen con amplio entrenamiento y experiencia en la detección de enfermedades mediante estudios de imagen. Me gradué de la Universidad Autónoma de Guadalajara (UAG) y realicé mi especialidad en Radiología en la UNAM, en el Hospital de Especialidades del Centro Médico Nacional Siglo XXI del IMSS.
He trabajado en instituciones como IMSS, Hospital Ángeles, Star Médica y Poliplaza en Ciudad Juárez, así como en laboratorios Chopo y Polanco. En 2014 fui profesor adjunto del programa de Radiología de la UNAM.
| Lunes – Viernes | 15:00 – 20:30 |
| Sábado | Emergencias |
| Domingo | Emergencias |
* Atención en fines de semana únicamente por emergencias con costo adicional.
Contáctanos por teléfono o WhatsApp — respondemos rápido